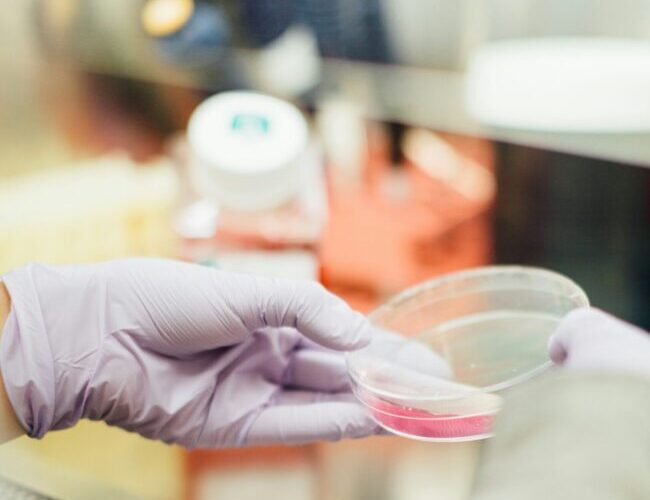

Lagförändringar: Nytt år, nya lagar!
Lagförändringar under det nya året 2024 kan innebära betydande föränringar som påverkar dig och ditt företag. Det är viktigt att hålla sig uppdaterad. Därför bjuder vi dig på en lättöverskådlig sammanfattning över några av de mest relevanta förändringarna:
Höjd jämförelseränta för ränteförmån
Från och med 1 januari 2024 ökar jämförelseräntan för ränteförmån med en halv procentenhet, vilket innebär att den blir statslåneräntan + 1,5 procentenheter. Vad betyder egentligen det här? Läs mer om det i vårat inlägg HÄR som förklarar det hela lite närmre. Kort och gott: detta påverkar beskattningen när anställda lånar pengar av arbetsgivaren.
Ingen uppräkning av skiktgränsen
Skiktgränsen för statlig skatt förblir oförändrad för 2024 och stannar på 598 500 kr, då den inte räknas upp enligt den vanliga metoden. Vad betyder detta? Läs mer HÄR!
Slopad nedsättning av arbetsgivaravgiften för 15–18 åringar
Från och med 1 januari 2024 slopas nedsättningen av arbetsgivaravgiften för ungdomar mellan 15 och 18 år, vilket innebär att arbetsgivaravgiften för denna åldersgrupp nu är 31,42%. Läs mer om ditt företag påverkas HÄR.
Höjt jobbskatteavdrag och sänkt skatt för pensionärer
Det ordinarie jobbskatteavdraget ökar med i genomsnitt 2 600 kr/år, samtidigt som förändringar gäller för äldre arbetskraft för att behålla dem på arbetsmarknaden. Hur påverkar detta ditt företag? Läs mer HÄR!
Förlängd expertskatt
Skattelättnaden för experter, forskare och nyckelpersoner utvidgas från att gälla i högst fem år till att nu omfatta högst sju år för att stärka Sveriges internationella konkurrenskraft. Läs mer HÄR!
Sänkt skatt på bensin och diesel
Energiskatten på bensin och diesel sänks, och reduktionsplikten för bensin och diesel minskas till 6%, vilket kan påverka ditt företags kostnader för bränsle. Resultat: 4 miljoner ton koldioxid extra i utsläpp. Läs mer om hur den sänkta skatten påverkar ditt företag HÄR!
Digitala bolags- och föreningsstämmor
Från och med 1 januari 2024 förenklas möjligheterna för digitala stämmor för olika bland annat aktiebolag, BRF:er och ekonomiska föreningar. Detta underlättar flexibiliteten och hanteringen av bolags- och föreningsangelägenheter. Det ska framgå av bolagsordningen att stämman får hållas digitalt.
Allframtidsupplåtelser – höjt belopp
Beloppet för omkostnadsberäkning vid engångsersättning för allframtidsupplåtelser höjs från 5 000 kr till 12 000 kr, vilket kan påverka ekonomin vid sådana överlåtelser. Fundersam på vad det innebär, eller ens betyder? Läs mer HÄR!
Förenklad modell för beräkning av FoU-avdraget
Reglerna för FoU-avdraget förenklas, och avdraget kan nu göras mot summan av arbetsgivaravgifter och den allmänna löneavgiften för personer som arbetar med forskning och utveckling. Läs mer om detta HÄR!
Håll koll på dessa lagförändringar för att optimera din verksamhet och anpassa dig till det nya skattemässiga landskapet! Det är väldigt viktigt att hålla sig uppdaterad kring skattelagstiftning och regeländringar, för att kunna dra full nytta av tillgängliga skatteförmåner och andra incitament som hjälper dig och ditt företag.
Känns det som mycket att hålla koll på? Fullt förståeligt, det är ju faktiskt ett heltidsjobb att sköta ett företags ekonomi. Skulle du hellre vilja lägga dina timmar på något annat än ekonomi? Hör av dig antingen via mail (info@yourcfo.se) eller på telefon 031-14 66 46. Vi är redo att ta emot dig med öppna armar!